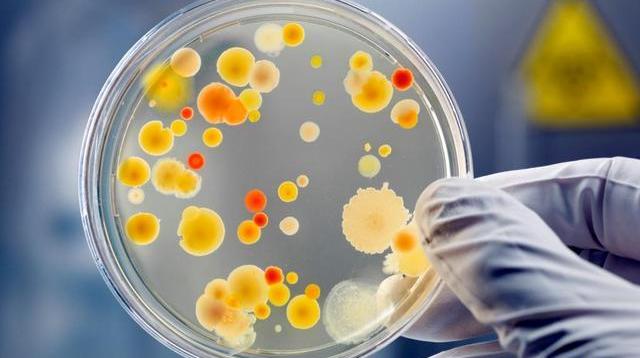

BTC/HKD-0.59%
ETH/HKD-0.98%
LTC/HKD-1.71%
ADA/HKD-1.22%
SOL/HKD-2.36%
XRP/HKD+0.25% 
本文參加百家號Billions項目組系列征文賽。
一項將在今年的歐洲臨床微生物學和傳染病大會的新研究表明,歐元紙幣比硬幣更容易受到微生物的污染。反過來說,歐元硬幣比紙幣更具抗菌的活性。來自德國漢堡大學醫學中心的約翰內斯·克諾布洛赫教授稱:即便硬幣由銅等抗菌金屬制成,但它們仍然是潛在的細菌、病污染源。

Ripple已與Lunu建立合作關系,為歐洲奢侈品零售店提供更快和更安全的數字資產支付選項:6月7日消息,Ripple已與加密初創公司Lunu建立合作關系,為歐洲各地的奢侈品零售店提供更快和更安全的數字資產支付選項。Lunu將利用Ripple的流動性中心,使顧客在零售店進行加密貨幣與法幣支付時能夠獲得最佳價格。
據悉,Ripple已經在中東地區開展業務,其2021年網絡支付量達150億美元。此外,Ripple還計劃通過此舉推動全球加密貨幣的采用。[2022/6/8 4:09:30]
在此前的很多研究中已經證實,現金有一個經常被許多個不同的人接觸的表面,被認為與病原體的傳播有關。由于歐元硬幣中銅的含量至少為75%,因此有研究認為這些零錢具有抗菌活性。
機構分析:預計歐洲央行將在夏季繼續加快其購債步伐:經濟學家和投資者越來越相信,盡管經濟可能出現反彈,歐洲央行料將在下次會議上加快其緊急購債步伐。近期歐洲央行官員一直在反駁有關該行準備放慢購債速度的說法。鑒于更加鷹派立場的官員在這一問題上相對沉默,更寬松的政策已成定勢。摩根大通經濟學家Greg Fuzesi在一份報告中表示:“這使得第三季度購買步伐‘顯著’加快的可能性得以延續,即使該決定可能在6月才做出,并需要作出部分妥協。” (金十)[2021/5/28 22:52:53]
在這項研究中,研究人員使用模擬皮膚接觸干污染的觸摸轉移分析法,在實際條件下研究了歐元硬幣和紙幣的抗菌活性。在實驗過程中,研究人員戴著的手套被沾染了一定量的細菌,這些細菌從一個干燥的表面傳播到硬幣或紙幣上,以模擬典型的經常接觸表面的“最壞情況”的污染。
動態 | 都柏林成歐洲區塊鏈新中心:據愛爾蘭獨立報消息,自英國脫歐消息不斷發酵以來,都柏林成為許多區塊鏈新貴公司的首選地, Coinbase上個月在都柏林開設了辦事處。對于許多從事新興技術的公司來說,這個島嶼的吸引力很大,例如布魯克林的區塊鏈初創公司 ConsenSys。區塊鏈技術存儲分布在網絡上的信息塊;他們已被許多業務垂直行業所接受,以實現他們為在線交易帶來的可追溯性和安全性。[2018/11/15]

公告 | 歐洲八大金融機構成功測試用于注冊權證發行的區塊鏈系統:據cointelegraph援引西班牙新聞出版社El Economista 6月25日的報道,歐洲八大金融機構宣布將共同開展區塊鏈技術項目,以記錄金融權證的發行情況。八大金融機構包括西班牙證券監管機構國家證券市場委員會(CNMV),主要股票市場運營商BME,桑坦德銀行,BBVA銀行,法國巴黎銀行,CaixaBank銀行,德國商業銀行和法國興業銀行。他們的合作已經“成功”完成了概念驗證。根據今天發布的聲明,該系統的創建目的是在48小時內完成認股權證的注冊,這一過程通常需要一周以上的時間。[2018/6/26]
5歐元紙幣和所有其他歐元紙幣一樣,是由棉纖維制成的。在1歐元和2歐元的硬幣,存在“黃金”部分和“白銀”部分。“黃金”部分是合金,含75%的銅,20%的鋅和5%的鎳。“白銀”部分是白銅:75%銅和25%鎳。10分、20分和50分的硬幣是由“北歐黃金”制成的,這種合金由89%的銅、5%的鋁、5%的鋅和1%的錫組成。5分、2分和1分的硬幣是由銅包鋼制成的。
研究人員用濕的無菌棉手套觸摸表面,接觸屎腸球菌或金黃色葡萄球菌,并將它們沾在手套上。通過受污染的手套,研究人員把細菌轉移到5分、50分和1歐元的硬幣以及5歐元的紙幣上。在接觸轉移試驗中,瓷磚被用作對照表面。硬幣和紙幣的定量培養在接觸后立即進行。
在使用屎腸球菌和金黃色葡萄球菌的9個獨立實驗中,作者發現在不同貨幣表面上觀察到了不同數量的轉移細菌。控制表面和鈔票的污染顯示出相似的細菌細胞計數。
與50分和1歐元硬幣相比,5分硬幣較小的表面導致的細菌轉移量較低。所有含銅硬幣都顯示出可檢測到的抗菌活性。24小時后,5分、50分和1歐元硬幣上的金黃色葡萄球菌數量分別減少了98.7%和99.5%,屎腸球菌數量分別減少了96.8%和99.0%。相反,在鈔票上放置24小時后,細菌細胞的數量與對照組相比沒有減少。

研究人員總結道:“與5歐元紙幣相比,含銅硬幣顯示出可檢測到的抗菌活性。然而,在大多數實驗中,細菌并沒有從硬幣中完全清除。因此,即使是硬幣也可能成為微生物傳播的載體。”
最近,研究還表明,含銅表面對COVID-19具有一定的抗病活性,顯著縮短了病保持傳染性的時間,而在紙幣中由棉纖維組成的聚合表面,病可以存活數天。

但研究人員解釋,通過硬幣,甚至紙幣傳播病的風險,遠遠低于人們面對面接觸的風險。關于目前流行的COVID-19,如果必須用現金支付,硬幣會比紙幣好。
讓我們感到稍微欣慰的是,無現金支付方式,早已在中國得到普及。我們可以選擇這種不需要紙幣或硬幣,甚至不需要跟收銀員或老板發生任何接觸的方式進行支付。在抗疫期間,我們根本不用擔心紙幣或硬幣會傳播細菌或病的可能性。

在抗擊新冠肺炎疫情期間,各地的實體商業幾乎都關門閉店、停工停業以減少人傳人感染。電商成為維系國民生活正常運轉的唯一渠道,在它發揮積極作用的同時,也爆出電商物流爆倉,配送短板待解.
1900/1/1 0:00:00把馬耳他打造成國際性商務平臺,在經濟發展上樹立楷模,始終在歐盟處于頂尖行列。馬耳他之所以能崛起成為歐洲一流金融中心,很大程度上要歸功于這座島國經商環境的穩定性、可預測性和安全性,使之在眾多的全球.
1900/1/1 0:00:00大家好,我是Cindy。在14年,從事翻譯工作時接觸到比特幣。17年2月份加入到巴比特,擔任當時國際站的英文記者,正式allin這個行業.
1900/1/1 0:00:00驕陽曾在去年寫過一篇關于穩定幣的文章《穩定幣恐將成為眾矢之的》,文中已經闡明了驕陽對穩定幣的觀點,穩定幣的發展形成了另一個資金池,拖累了牛市的到來.
1900/1/1 0:00:00賈政,榮國府的當家人。 他每日只看書下棋,同一幫清客閑聊,從不管府中的大小事務,一切委托侄媳婦王熙鳳來料理,倒也落了個清閑。這里,筆者就以賈政為主線,來扒一扒賈府各人的每月薪水.
1900/1/1 0:00:00疫情不斷蔓延,當所有人還在關注每日確診人數時,一個由疫情引發的多米諾骨牌效應正在全球經濟中發生,多個原本經濟就脆弱的國家,在疫情之下商業受阻,經濟崩盤進而貨幣瘋狂貶值.
1900/1/1 0:00:00